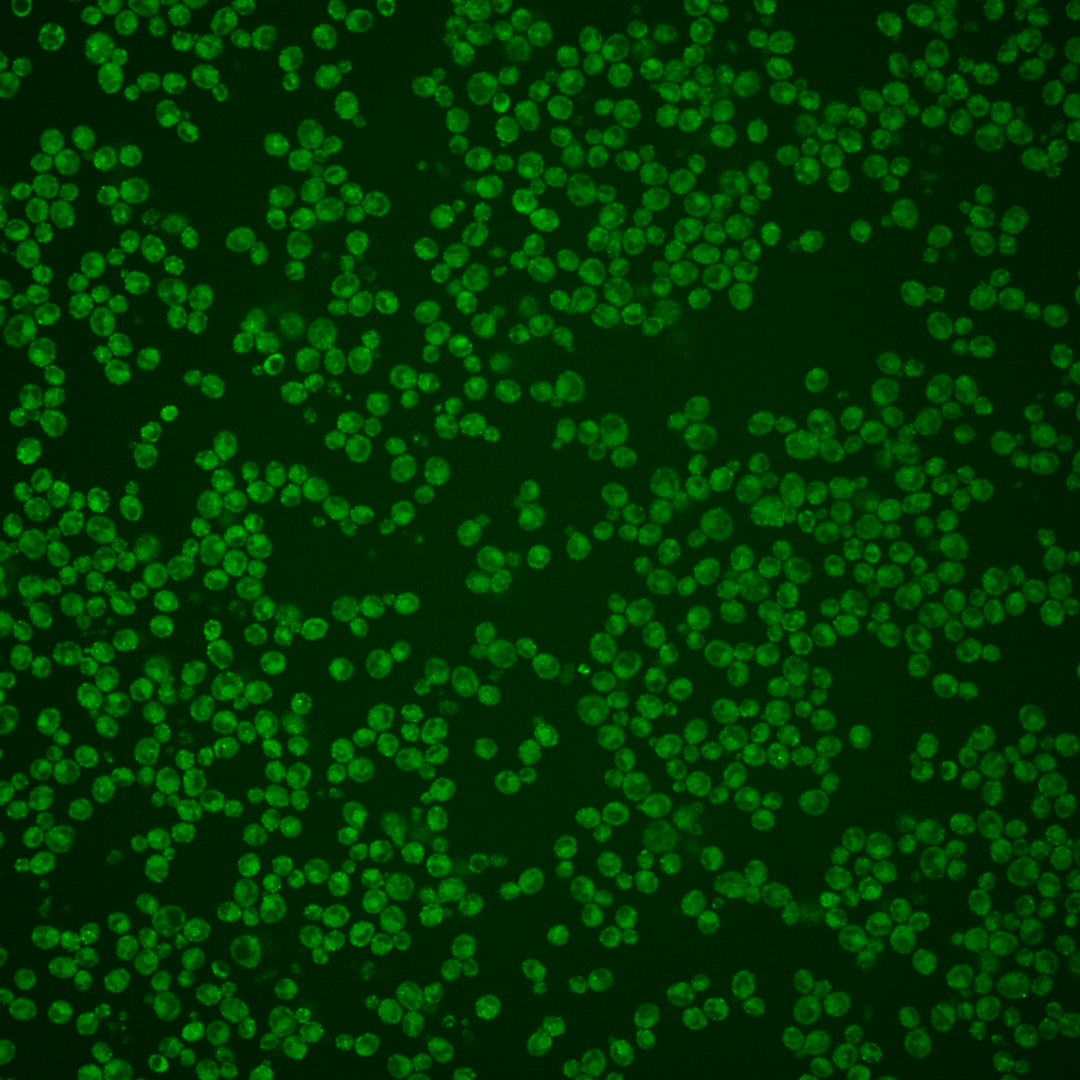
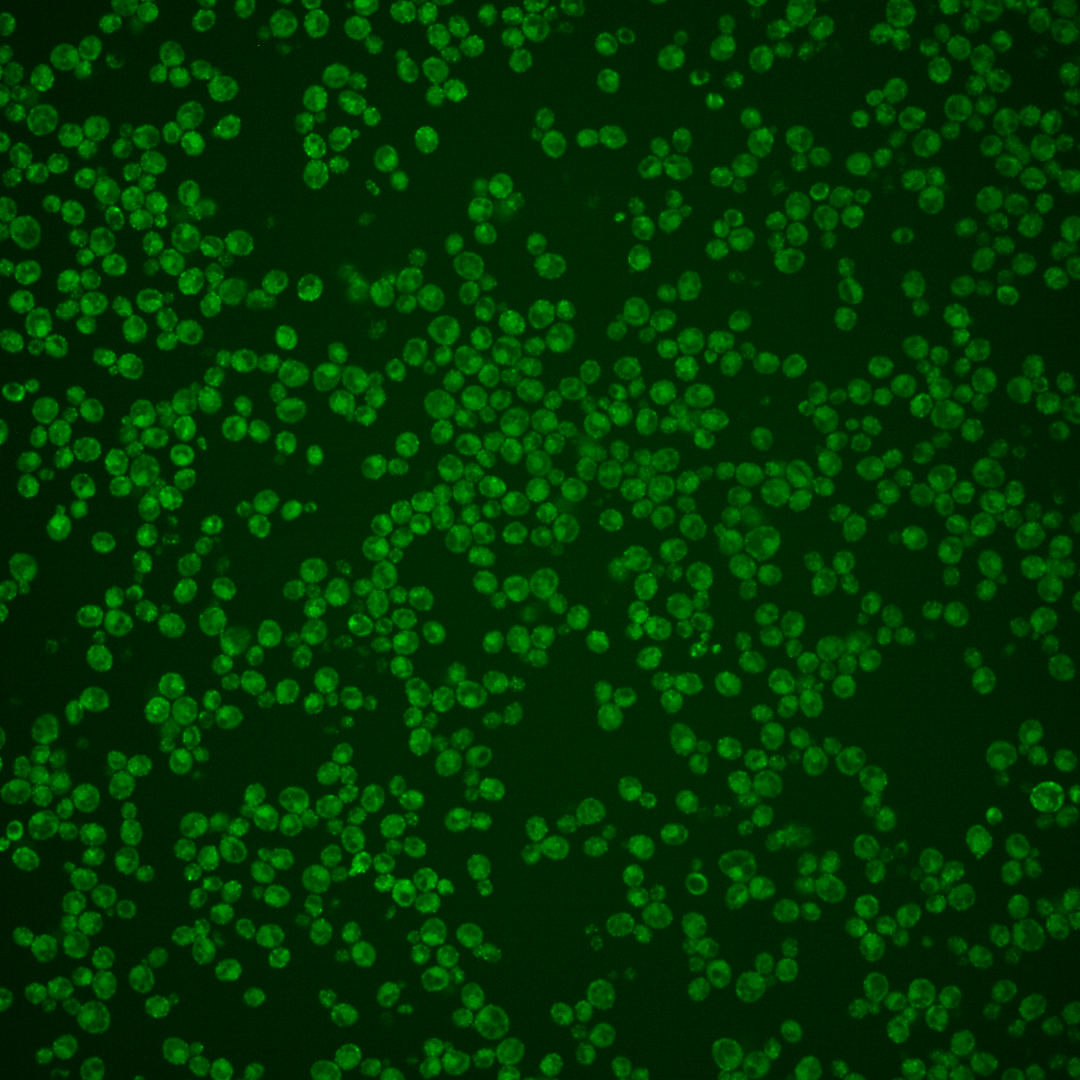

| Standard name | |
|---|---|
| Human Ortholog | |
| Description | Serine esterase; homolog of human neuropathy target esterase (NTE); Nte1p-mediated phosphatidylcholine turnover influences transcription factor Opi1p localization, affecting transcriptional regulation of phospholipid biosynthesis genes |
Micrographs




















































































Sub-cellular Localization
Yeast GFP Assignment
Protein Abundance
Localization Change
External localization resources
| ensLOC | DeepLoc | |||||||||||||||||||||||
|---|---|---|---|---|---|---|---|---|---|---|---|---|---|---|---|---|---|---|---|---|---|---|---|---|
| Localization | WT1 | WT2 | WT3 | RAP60 | RAP140 | RAP220 | RAP300 | RAP380 | RAP460 | RAP540 | RAP620 | RAP700 | HU80 | HU120 | HU160 | rpd3Δ_1 | rpd3Δ_2 | rpd3Δ_3 | WT1 | WT2 | WT3 | AF100 | AF140 | AF180 |
| Cortical Patches | 77 | 127 | 79 | 73 | 20 | 53 | 39 | 26 | 40 | – | 20 | 3 | 50 | 111 | 122 | 62 | 64 | 73 | 110 | 159 | 156 | 69 | 111 | 139 |
| Bud | 10 | 14 | 33 | 29 | 42 | 31 | 50 | 68 | 61 | – | 53 | 31 | 9 | 24 | 31 | 3 | 4 | 5 | 0 | 2 | 0 | 0 | 2 | 1 |
| Bud Neck | 1 | 0 | 0 | 0 | 0 | 0 | 0 | 2 | 0 | – | 0 | 0 | 0 | 1 | 0 | 0 | 0 | 0 | 2 | 16 | 5 | 10 | 7 | 9 |
| Bud Site | 1 | 3 | 1 | 1 | 1 | 5 | 4 | 4 | 7 | – | 6 | 5 | 0 | 1 | 1 | 0 | 0 | 1 | – | – | – | – | – | – |
| Cell Periphery | 16 | 32 | 26 | 26 | 14 | 12 | 14 | 15 | 18 | – | 17 | 21 | 13 | 30 | 70 | 16 | 22 | 20 | 11 | 14 | 20 | 12 | 20 | 38 |
| Cytoplasm | 32 | 63 | 37 | 43 | 38 | 52 | 77 | 115 | 49 | – | 34 | 60 | 25 | 53 | 60 | 37 | 27 | 33 | 2 | 6 | 1 | 3 | 8 | 6 |
| Endoplasmic Reticulum | 91 | 201 | 77 | 41 | 50 | 62 | 63 | 40 | 61 | – | 25 | 17 | 53 | 91 | 73 | 8 | 8 | 13 | 134 | 152 | 73 | 44 | 76 | 68 |
| Endosome | 12 | 2 | 12 | 6 | 20 | 5 | 21 | 23 | 3 | – | 0 | 10 | 1 | 4 | 0 | 11 | 9 | 16 | 4 | 11 | 10 | 5 | 6 | 9 |
| Golgi | 5 | 3 | 2 | 0 | 0 | 0 | 0 | 0 | 0 | – | 0 | 0 | 1 | 0 | 0 | 24 | 46 | 40 | 9 | 16 | 18 | 5 | 6 | 9 |
| Mitochondria | 23 | 62 | 82 | 139 | 109 | 164 | 259 | 352 | 367 | – | 271 | 321 | 14 | 45 | 67 | 14 | 26 | 15 | 25 | 38 | 37 | 21 | 37 | 35 |
| Nucleus | 1 | 0 | 1 | 2 | 1 | 0 | 0 | 3 | 1 | – | 0 | 1 | 2 | 0 | 0 | 0 | 2 | 1 | 0 | 0 | 0 | 0 | 0 | 0 |
| Nuclear Periphery | 0 | 0 | 0 | 0 | 0 | 1 | 0 | 0 | 0 | – | 1 | 2 | 0 | 0 | 0 | 0 | 0 | 0 | 0 | 0 | 0 | 0 | 0 | 0 |
| Nucleolus | 0 | 0 | 0 | 0 | 0 | 0 | 0 | 0 | 0 | – | 1 | 1 | 0 | 0 | 0 | 0 | 0 | 1 | 0 | 0 | 0 | 0 | 0 | 0 |
| Peroxisomes | 15 | 5 | 29 | 29 | 96 | 20 | 43 | 58 | 36 | – | 18 | 18 | 4 | 12 | 10 | 18 | 15 | 35 | 4 | 3 | 16 | 2 | 7 | 7 |
| SpindlePole | 2 | 2 | 8 | 2 | 11 | 3 | 10 | 27 | 10 | – | 9 | 7 | 0 | 4 | 3 | 15 | 23 | 22 | 0 | 0 | 0 | 0 | 0 | 0 |
| Vac/Vac Membrane | 10 | 7 | 7 | 0 | 2 | 1 | 4 | 10 | 2 | – | 5 | 11 | 0 | 0 | 1 | 5 | 5 | 11 | 3 | 15 | 8 | 6 | 13 | 8 |
| Unique Cell Count | 224 | 377 | 271 | 254 | 289 | 286 | 429 | 569 | 480 | 332 | 394 | 126 | 279 | 318 | 165 | 168 | 191 | 313 | 443 | 352 | 184 | 304 | 338 | |
| Labelled Cell Count | 296 | 521 | 394 | 391 | 404 | 409 | 584 | 743 | 655 | 460 | 508 | 172 | 376 | 438 | 213 | 251 | 286 | 313 | 443 | 352 | 184 | 304 | 338 | |
Yeast GFP Assignment
Protein Abundance
| Screen | WT1 | WT2 | WT3 | RAP60 | RAP140 | RAP220 | RAP300 | RAP380 | RAP460 | RAP540 | RAP620 | RAP700 | HU80 | HU120 | HU160 | rpd3Δ_1 | rpd3Δ_2 | rpd3Δ_3 | AF100 | AF140 | AF180 |
|---|---|---|---|---|---|---|---|---|---|---|---|---|---|---|---|---|---|---|---|---|---|
| Mean Cell GFP Intensity (1e-4) | 7.1 | 6.0 | 5.4 | 5.1 | 5.1 | 4.8 | 4.6 | 4.4 | 4.0 | – | 3.9 | 3.7 | 5.5 | 5.7 | 5.4 | 8.6 | 9.3 | 9.9 | 6.3 | 6.3 | 6.6 |
| Std Deviation (1e-4) | 1.4 | 1.0 | 0.8 | 1.3 | 1.6 | 1.4 | 1.5 | 1.4 | 1.1 | – | 1.1 | 0.8 | 1.0 | 0.9 | 0.9 | 1.7 | 2.1 | 2.3 | 1.2 | 1.3 | 1.4 |
| Intensity Change (Log2) | – | – | – | -0.06 | -0.07 | -0.16 | -0.22 | -0.29 | -0.41 | – | -0.45 | -0.54 | 0.05 | 0.08 | 0.02 | 0.69 | 0.8 | 0.88 | 0.24 | 0.24 | 0.29 |
Localization Change
| Localization | RAP60 | RAP140 | RAP220 | RAP300 | RAP380 | RAP460 | RAP540 | RAP620 | RAP700 | HU80 | HU120 | HU160 | rpd3Δ_1 | rpd3Δ_2 | rpd3Δ_3 |
|---|---|---|---|---|---|---|---|---|---|---|---|---|---|---|---|
| Cortical Patches | -0.1 | -6.9 | 0 | 0 | 0 | 0 | – | 0 | 0 | 2.1 | 2.6 | 2.4 | 1.8 | 1.9 | 2.0 |
| Bud | -0.3 | 0.8 | 0 | 0 | 0 | 0 | – | 0 | 0 | -1.5 | -1.4 | -0.9 | -3.8 | -3.6 | -3.7 |
| Bud Neck | 0 | 0 | 0 | 0 | 0 | 0 | – | 0 | 0 | 0 | 0 | 0 | 0 | 0 | 0 |
| Bud Site | 0 | 0 | 0 | 0 | 0 | 0 | – | 0 | 0 | 0 | 0 | 0 | 0 | 0 | 0 |
| Cell Periphery | 0.2 | -2.2 | 0 | 0 | 0 | 0 | – | 0 | 0 | 0.2 | 0.4 | 4.1 | 0 | 1.1 | 0.3 |
| Cytoplasm | 1.0 | -0.2 | 1.5 | 1.5 | 2.3 | -1.4 | – | -1.3 | 0.6 | 1.6 | 1.7 | 1.7 | 2.4 | 0.7 | 1.1 |
| Endoplasmic Reticulum | -3.4 | -3.1 | 0 | 0 | 0 | 0 | – | 0 | 0 | 2.7 | 1.1 | -1.5 | -6.0 | -6.1 | -5.8 |
| Endosome | -1.3 | 1.3 | 0 | 0 | 0 | 0 | – | 0 | 0 | 0 | -2.1 | -3.8 | 1.0 | 0.4 | 1.8 |
| Golgi | 0 | 0 | 0 | 0 | 0 | 0 | – | 0 | 0 | 0 | 0 | 0 | 5.9 | 8.7 | 7.4 |
| Mitochondria | 5.7 | 1.9 | 0 | 0 | 0 | 0 | – | 0 | 0 | -4.1 | -3.9 | -2.6 | -5.3 | -3.5 | -5.8 |
| Nucleus | 0 | 0 | 0 | 0 | 0 | 0 | – | 0 | 0 | 0 | 0 | 0 | 0 | 0 | 0 |
| Nuclear Periphery | 0 | 0 | 0 | 0 | 0 | 0 | – | 0 | 0 | 0 | 0 | 0 | 0 | 0 | 0 |
| Nucleolus | 0 | 0 | 0 | 0 | 0 | 0 | – | 0 | 0 | 0 | 0 | 0 | 0 | 0 | 0 |
| Peroxisomes | 0.3 | 6.4 | 0 | 0 | 0 | 0 | – | 0 | 0 | -2.5 | -2.9 | -3.7 | 0.1 | -0.6 | 2.3 |
| SpindlePole | 0 | 0.6 | 0 | 0 | 0 | 0 | – | 0 | 0 | 0 | -1.2 | -1.8 | 2.8 | 4.3 | 3.7 |
| Vacuole | 0 | 0 | 0 | 0 | -0.8 | 0 | – | -0.9 | 0.2 | 0 | 0 | 0 | 0 | 0 | 1.7 |
External localization resources
Images






























Protein Concentration and Protein Localization Data
| R1 | R2 | R3 | ||||||||||||||||
|---|---|---|---|---|---|---|---|---|---|---|---|---|---|---|---|---|---|---|
| G1 Pre-START | G1 Post-START | S/G2 | Metaphase | Anaphase | Telophase | G1 Pre-START | G1 Post-START | S/G2 | Metaphase | Anaphase | Telophase | G1 Pre-START | G1 Post-START | S/G2 | Metaphase | Anaphase | Telophase | |
| Concentration | 5.1914 | 4.7543 | 4.9386 | 4.8479 | 3.7366 | 4.5358 | 2.4291 | 3.3579 | 3.502 | 2.8633 | 2.3312 | 2.8331 | 4.2247 | 4.1868 | 4.3522 | 4.2006 | 3.8503 | 3.5147 |
| Actin | 0.1755 | 0.1349 | 0.2396 | 0.2338 | 0.166 | 0.1831 | 0.171 | 0.1213 | 0.1459 | 0.22 | 0.305 | 0.1427 | 0.2411 | 0.1918 | 0.2761 | 0.2681 | 0.3451 | 0.2437 |
| Bud | 0.0015 | 0.0021 | 0.0043 | 0.0032 | 0.0037 | 0.001 | 0.0212 | 0.0019 | 0.0152 | 0.0026 | 0.0006 | 0.0012 | 0.0008 | 0.0028 | 0.0154 | 0.0008 | 0.0029 | 0.0019 |
| Bud Neck | 0.0222 | 0.0108 | 0.0333 | 0.0438 | 0.0692 | 0.0983 | 0.0304 | 0.0091 | 0.0162 | 0.0094 | 0.0076 | 0.1034 | 0.0144 | 0.0088 | 0.0189 | 0.0521 | 0.0397 | 0.0693 |
| Bud Periphery | 0.006 | 0.004 | 0.0188 | 0.0292 | 0.0394 | 0.0039 | 0.0138 | 0.0018 | 0.006 | 0.0074 | 0.0013 | 0.0039 | 0.0023 | 0.0055 | 0.0186 | 0.0088 | 0.0222 | 0.0076 |
| Bud Site | 0.0134 | 0.106 | 0.0379 | 0.003 | 0.0456 | 0.0029 | 0.0547 | 0.1023 | 0.0241 | 0.0138 | 0.0026 | 0.002 | 0.013 | 0.0992 | 0.0693 | 0.0029 | 0.0131 | 0.0064 |
| Cell Periphery | 0.0315 | 0.0159 | 0.0286 | 0.0563 | 0.0123 | 0.0179 | 0.0298 | 0.031 | 0.0322 | 0.0236 | 0.0195 | 0.0303 | 0.0303 | 0.0312 | 0.0443 | 0.063 | 0.046 | 0.0207 |
| Cytoplasm | 0.1652 | 0.231 | 0.2119 | 0.2407 | 0.151 | 0.2681 | 0.1754 | 0.3491 | 0.2875 | 0.2735 | 0.1332 | 0.2599 | 0.1853 | 0.2062 | 0.1871 | 0.1097 | 0.1292 | 0.3406 |
| Cytoplasmic Foci | 0.0764 | 0.0884 | 0.0766 | 0.0279 | 0.0371 | 0.069 | 0.0866 | 0.0645 | 0.0744 | 0.0697 | 0.0989 | 0.0972 | 0.0777 | 0.0692 | 0.06 | 0.047 | 0.0752 | 0.0652 |
| Eisosomes | 0.0054 | 0.0017 | 0.0045 | 0.01 | 0.0047 | 0.0033 | 0.0055 | 0.0039 | 0.0037 | 0.0035 | 0.006 | 0.0028 | 0.0073 | 0.0065 | 0.0093 | 0.0242 | 0.0219 | 0.0032 |
| Endoplasmic Reticulum | 0.0654 | 0.0865 | 0.0992 | 0.0562 | 0.1124 | 0.1094 | 0.0495 | 0.0487 | 0.0698 | 0.151 | 0.1845 | 0.0945 | 0.0715 | 0.0888 | 0.0338 | 0.0962 | 0.0492 | 0.0612 |
| Endosome | 0.07 | 0.0579 | 0.0442 | 0.0377 | 0.0767 | 0.0489 | 0.0345 | 0.0277 | 0.0461 | 0.065 | 0.0287 | 0.0431 | 0.0694 | 0.0483 | 0.0221 | 0.0159 | 0.0287 | 0.0315 |
| Golgi | 0.0567 | 0.071 | 0.0596 | 0.0623 | 0.0525 | 0.0616 | 0.0211 | 0.0388 | 0.0682 | 0.0499 | 0.0889 | 0.0626 | 0.0589 | 0.0605 | 0.0441 | 0.0615 | 0.0812 | 0.0366 |
| Lipid Particles | 0.1589 | 0.1176 | 0.0696 | 0.0354 | 0.093 | 0.0767 | 0.1639 | 0.0659 | 0.0796 | 0.0738 | 0.0889 | 0.0889 | 0.0888 | 0.0573 | 0.058 | 0.0288 | 0.0752 | 0.0308 |
| Mitochondria | 0.015 | 0.0062 | 0.0165 | 0.0465 | 0.0514 | 0.0161 | 0.0076 | 0.0016 | 0.0253 | 0.0045 | 0.0021 | 0.0234 | 0.0055 | 0.0047 | 0.0045 | 0.0038 | 0.0108 | 0.0053 |
| None | 0.043 | 0.0405 | 0.0308 | 0.0618 | 0.052 | 0.0237 | 0.0968 | 0.1086 | 0.0787 | 0.0114 | 0.0037 | 0.0247 | 0.097 | 0.1074 | 0.1217 | 0.1955 | 0.0374 | 0.0579 |
| Nuclear Periphery | 0.0342 | 0.004 | 0.0045 | 0.0082 | 0.0031 | 0.0022 | 0.0034 | 0.0034 | 0.0091 | 0.0018 | 0.0017 | 0.0015 | 0.0048 | 0.0012 | 0.0013 | 0.0009 | 0.0017 | 0.0015 |
| Nucleolus | 0.0009 | 0.0005 | 0.0004 | 0.0003 | 0.0002 | 0.0002 | 0.0014 | 0.0007 | 0.0006 | 0.0002 | 0.0001 | 0.0002 | 0.0006 | 0.0003 | 0.0008 | 0.0002 | 0.0005 | 0.0003 |
| Nucleus | 0.0063 | 0.0012 | 0.0012 | 0.0017 | 0.0007 | 0.0008 | 0.0028 | 0.0014 | 0.0047 | 0.0007 | 0.0003 | 0.0008 | 0.0008 | 0.0005 | 0.0031 | 0.0003 | 0.0006 | 0.001 |
| Peroxisomes | 0.031 | 0.0121 | 0.0091 | 0.0017 | 0.0205 | 0.007 | 0.0186 | 0.0035 | 0.0045 | 0.0096 | 0.0236 | 0.0113 | 0.0207 | 0.0062 | 0.006 | 0.0163 | 0.0141 | 0.0087 |
| Punctate Nuclear | 0.0127 | 0.0021 | 0.0034 | 0.0007 | 0.0009 | 0.0011 | 0.0062 | 0.0113 | 0.002 | 0.0011 | 0.0011 | 0.0015 | 0.0031 | 0.0009 | 0.0018 | 0.0006 | 0.0024 | 0.0014 |
| Vacuole | 0.0055 | 0.0049 | 0.0051 | 0.0219 | 0.0052 | 0.004 | 0.0049 | 0.0032 | 0.005 | 0.0067 | 0.0013 | 0.0031 | 0.0053 | 0.0024 | 0.0035 | 0.0033 | 0.0023 | 0.0047 |
| Vacuole Periphery | 0.0032 | 0.0007 | 0.001 | 0.0175 | 0.0023 | 0.0009 | 0.001 | 0.0003 | 0.0012 | 0.0008 | 0.0004 | 0.0008 | 0.0014 | 0.0004 | 0.0004 | 0.0003 | 0.0007 | 0.0006 |
Sequencing Data
| R1 | R2 | |||||||||
|---|---|---|---|---|---|---|---|---|---|---|
| G1 Post-START | S/G2 | Metaphase | Anaphase | Telophase | G1 Post-START | S/G2 | Metaphase | Anaphase | Telophase | |
| Gene Expression | 38.4221 | 27.595 | 29.045 | 30.7228 | 25.8305 | 32.8212 | 34.1346 | 32.4543 | 31.86 | 37.4555 |
| Translational Efficiency | 0.4441 | 0.3639 | 0.3688 | 0.3567 | 0.2953 | 0.4868 | 0.3752 | 0.3564 | 0.4038 | 0.3427 |
Hit Data
| Dataset | Hit |
|---|---|
| Protein Concentration | ✘ |
| Protein Localization | ✘ |
| Gene Expression | ✘ |
| Translational Efficiency | ✘ |
Endocytosis
| Temp | Actin Patch (Sac6-tdTomato) | Cortical Patch (Sla1-GFP) | Late Endosome (Snf7-GFP) | Vacuole (Vph1-GFP) |
|---|---|---|---|---|
| 37℃ | ||||
| RT |
Cell Cycle Omics
CYCLoPs (Nte1-GFP)
| Gene / Allele | Actin Patch (Sac6-tdTomato) | Cortical Patch (Sla1-GFP) | Late Endosome (Snf7-GFP) | Vacuole (Sac6-tdTomato) |
|---|
| Gene | Images |
|---|
| Gene | Images |
|---|
Images are not yet available
Images are not yet available